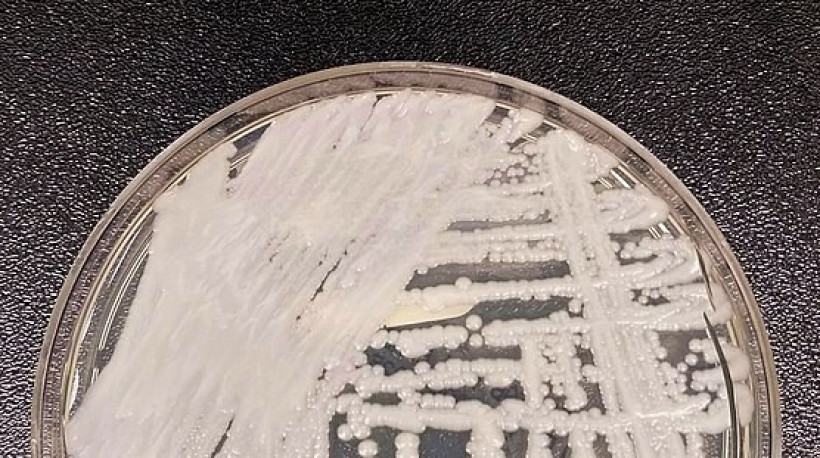

Candida auris: o que se sabe sobre os casos confirmados em Belo Horizonte?
O "superfungo" já infectou pelo menos quatro pacientes no Hospital João XIII, em Minas Gerais. 24 pessoas estão sendo monitoradas e aguardam resultados sem sintomas
A cidade de Belo Horizonte, capital de Minas Gerais, registrou quatro casos de infecção pelo “superfungo” Candida auris até a última quarta-feira, 16. Segundo a Secretaria de Estado de Saúde de Minas Gerais (SES-MG), dois pacientes receberam alta e um permanece internado no Hospital João XXIII, local de foco dos casos no município.
VEJA por que o Candida auris é conhecido como superfungo
É + que streaming. É arte, cultura e história.
Um dos infectados faleceu, mas a morte foi causada pelo estado de saúde grave em que se encontrava anteriormente. A SES-MG afirmou ter localizado cada paciente que teve contato com algum dos casos, seja na enfermaria ou no CTI. Dessas suspeitas, 27 pessoas estão sendo monitoradas e aguardam resultados sem sintomas.
Sintomas do superfungo Candida auris

A infecção pelo C. auris não gera sintomas específicos e é resistente aos medicamentos mais comuns para tratamentos de infecção por cândida. O superfungo pode infectar a corrente sanguínea e outras infecções invasivas, podendo ser fatal para os imunodeprimidos e para as pessoas com comorbidades
Estimativas apontam que de 30% a 60% dos contaminados morrem em decorrência da infecção.
Os quadros geralmente se iniciam com febre e calafrios, mas os sintomas podem evoluir. O fungo se instala em diferentes partes do organismo, até mesmo no interior dos tecidos, e pode ser detectado apenas por meio de exames laboratoriais específicos.
Nos casos de Belo Horizonte, eles estão sendo feitos pelo Laboratório Central de Saúde Pública da Fundação Ezequiel Dias (Lacen-MG/Funed), fora do hospital.
Como o superfungo foi transmitido em BH?
De acordo com o secretário estadual de saúde, Fábio Baccheretti, o Candidas auris provavelmente veio de um paciente que esteve na Colômbia, onde infecções pelo agente já são recorrentes.
Embora o mecanismo de transmissão ainda não seja completamente conhecido, evidências sugerem que o fungo se espalha por superfícies e equipamentos em áreas próximas a pacientes infectados. Ele é capaz de se manter vivo tanto em tecidos vivos quanto em superfícies inertes, sendo resistente a antifúngicos e a desinfetantes.
Candida auris: como prevenir e tratar?
A SES-MG destaca que o fungo tem alta transmissibilidade e capacidade de colonizar rapidamente a pele do paciente e o ambiente próximo a ele. É fundamental a prevenção de contato com casos suspeitos; por isso, os leitos são mantidos isolados.
É recomendado pela nota técnica da Anvisa que todos os profissionais da saúde envolvidos no controle de surtos de Candida auris adotem rigorosamente as medidas de prevenção. São elas: a higiene das mãos, o uso adequado de equipamentos de proteção individual (EPIs), e a limpeza e desinfecção de superfícies e equipamentos hospitalares.
As infecções por C. auris são tratadas com combinações de medicamentos fungicidas. No geral, as opções de tratamento são limitadas pela multiresistência do superfungo às três classes principais de antifúngicos: azóis, equinocandinas e polienos. Universidades e laboratórios vem estudando e desenvolvendo protocolos para combater o microrganismo.
Casos de Candida auris no Brasil
O fungo é reconhecido desde 2009 como agente prejudicial a humanos após infectar uma mulher japonesa. A primeira ocorrência do Candida auris no Brasil foi identificada pela Agência Nacional de Vigilância Sanitária (Anvisa) em dezembro de 2020, em Salvador, na Bahia. Na época, o órgão emitiu um comunicado alertando sobre o caso suspeito, apontando a alta resistência do microrganismo aos medicamentos antifúngicos e informando ações tomadas por uma força-tarefa.
Este surto do fungo na Bahia, o primeiro no País, resultou em 15 infecções e duas mortes. Um ano depois, em dezembro de 2021, ainda no mesmo estado, aconteceu o segundo alerta para o Candida auris, com somente um caso registrado durante seis meses de monitoramento.
O terceiro período de atenção ao superfungo no Brasil foi inicialmente reconhecido em dois pacientes, um homem de 38 anos e uma mulher de 70 anos, internados em um mesmo hospital de Recife, capital de Pernambuco. Dessa vez, o quadro foi mais grave, com 48 casos catalogados no início de 2022.
Mais dois alertas aconteceram em Pernambuco: um com apenas um caso e finalizado após um semestre de observação; e outro em três hospitais diferentes em 2023, com registro de nove casos. No mesmo ano, o estado de São Paulo também relatou um caso de infecção pelo fungo em um recém-nascido internado.
Superfungo em MG: próximos passos
A SES-MG afirma estar trabalhando junto ao Hospital João XXIII, onde o fungo se manifestou, e à Fundação Hospitalar do Estado de Minas Gerais (Fhemig), fazendo o controle epidemiológico de vigilância desses casos. O hospital está realizando testes rotineiros nos pacientes que tiveram proximidade aos quatro casos e liberando os negativados.
“Isso é uma rotina de diversos hospitais mundo afora. Temos bactérias multirresistentes, superbactérias e temos agora esse fungo”, afirmou Fábio Baccheretti, secretário estadual de saúde, em vídeo publicado pelo jornal O Tempo.
Baccheretti ainda completou que o fungo não está se espalhando pela sociedade. Por enquanto, a preocupação é apenas com os pacientes infectados no hospital, pois o C. auris afeta fortemente as pessoas imunocomprometidas.
Dúvidas, Críticas e Sugestões? Fale com a gente
